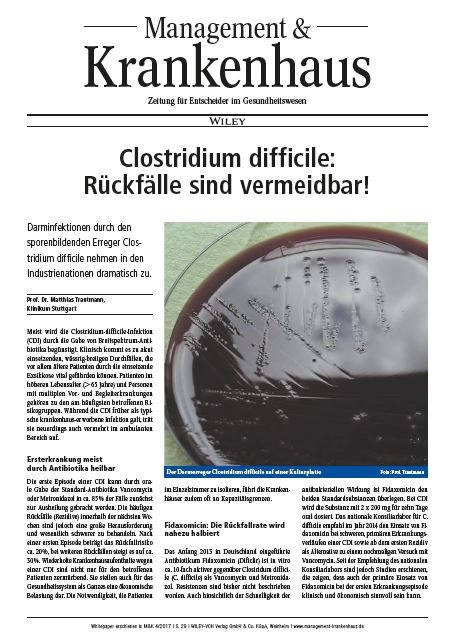
Darminfektionen durch den sporenbildenden Erreger Clostridium difficile nehmen...

Clostridium difficile: Rückfälle sind vermeidbar
Meist wird die Clostridium-difficile-Infektion (CDI) durch die Gabe von Breitspektrum-Antibiotika begünstigt. Klinisch kommt es zu akut einsetzenden, wässrig-breiigen Durchfällen, die vor allem ältere Patienten durch die einsetzende Exsikkose vital gefährden können. Patienten im höheren Lebensalter (> 65 Jahre) und Personen mit multiplen Vor- und Begleiterkrankungen gehören zu den am häufigsten betroffenen Risikogruppen. Während die CDI früher als typische krankenhaus-erworbene Infektion galt, tritt sie neuerdings auch vermehrt im ambulanten Bereich auf.







